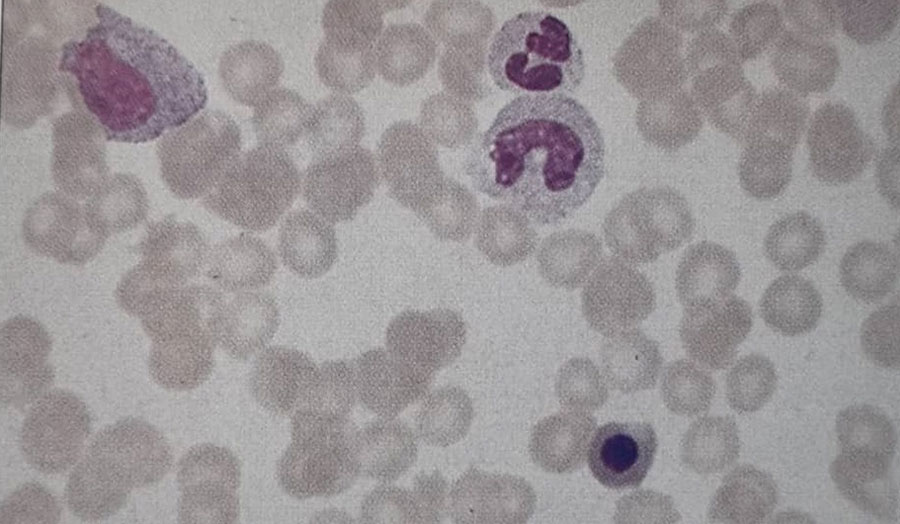
گسترش خون محیطی بیمار

مطالعه موردی بیمار شماره 63، تشخیص شما چیست؟
شرح حال بیمار
مردی ۶۵ ساله 4 هفته است که دچار کمردرد شده است. از نظر سایر موارد حال عمومی خوبی دارد. نتایج آزمایش شمارش کامل خون او به شرح زیر است:
Hb (هموگلوبین):1 g/dl
WBC (شمارش گلبول سفید): 7 × 10⁹/L
نوتروفیلها: 62٪
لنفوسیتها: 31٪
متامیلوسیتها: 2٪
میلوسیتها: 1٪
مونوسیتها: 2٪
ائوزینوفیلها: 1٪
بازوفیلها: 1٪
Platelets (پلاکت): 137 × 10⁹/L
NRBC : WBC: نسبت 1:100
(نسبت گلبولهای قرمز هستهدار به گلبولهای سفید)
ESR: 82 mm/hour

سوالات و پاسخها
1. نظر شما در مورد شمارش افتراقی گلبولهای سفید و گسترش خون محیطی بیمار چیست؟ (شکل 63a)
گسترش خون بیمار وضعیت لکواریتروبلاستیک (Leukoerythroblastic blood film) را نشان میدهد که نشاندهنده نفوذ مغز استخوان توسط سلولهای غیرمیلوئیدی آبنرمال است. این یافته اندیکاسیونی برای بررسی مغز استخوان محسوب میشود .
2. نظر شما در مورد آسپیراسیون مغز استخوان (شکل 63b) و بیوپسی ترفین (شکل 63c) چیست؟
آسپیراسیون و بیوپسی ترفین مغز استخوان نشاندهنده نفوذ سلولهای غیرطبیعی هستند؛ عناصر غدهای (glandular elements) بهوضوح در بیوپسی ترفین دیده میشوند. این نما با کارسینوم ثانویه (متاستاتیک) سازگار است. بیمار همچنین دچار کمردرد میباشد.
همچنین سلولهایی از کارسینوم معده در یک آسپیراسیون مغز استخوان (شکل 63d) و بیوپسی ترفین کارسینوم سلول اوت (Oat cell carcinoma) برونش در تصویر دیگری نشان داده شدهاند . (شکل 63e)
3. چه آزمایشهای تکمیلی دیگری لازم است؟
سطح آنتیژن اختصاصی پروستات (PSA) افزایش یافته بود. سلولهای موجود در آسپیراسیون از نظر فسفاتاز اسیدی مثبت بودند و اسکن استخوان نیز وجود رسوبات ثانویه (متاستاز) را نشان داد. معاینه رکتال و بیوپسی پروستات تشخیص را تأیید کردند.
بیمار تحت پروستاتکتومی رتروپوبیک قرار گرفت، اما پس از عمل دچار هماچوری شدید شد که علیرغم شستوشوی مکرر مثانه به مدت ۱۲ ساعت ادامه داشت. آزمایشها نشان دادند:
Hb (هموگلوبین): 1 g/dl
Platelets (پلاکت): 151 × 10⁹/L
PT 15 seconds (control 11-13 seconds)
APTT 45 seconds (control 30-40 seconds)
APTT mix with normal plasma:50:50 35 seconds
Thrombin time 40 seconds (control 12-20 seconds)
Fibrinogen 0.01 (NR 0.2-0.4 g/l)
Fibrin degradation products (FDP) >1:160 (NR <1:10)
هموگلوبین بیمار کاهش یافته و او نیازمند درمان با فرآوردههای خونی است.
انعقاد منتشر داخل عروقی (DIC) یک احتمال مطرح است، اما شمارش پلاکت طبیعی میباشد.
طولانی شدن زمان پروترومبین (PT)، کاهش شدید سطح فیبرینوژن و افزایش FDP پس از جراحی پروستات، مطرحکننده هایپرفیبرینولیز (Hyperfibrinolysis) است. بستر پروستات منبع غنی از فعالکنندههای پلاسمینوژن میباشد که باعث تخریب فیبرین میشوند؛ بنابراین D-dimer (که از تخریب فیبرین نیز ایجاد میشود) افزایش خواهد یافت.
بیمار باید تحت درمان با ترانگزامیک اسید (Tranexamic acid) یا EACA (ε-aminocaproic acid) قرار گیرد که هر دو مهارکنندههای اختصاصی فعالکنندههای پلاسمینوژن هستند.


